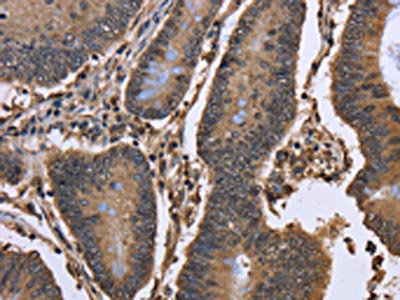

DCP1A Antibody
-
中文名稱:DCP1A兔多克隆抗體
-
貨號(hào):CSB-PA086956
-
規(guī)格:¥1100
-
圖片:
-
The image on the left is immunohistochemistry of paraffin-embedded Human cervical cancer tissue using CSB-PA086956(DCP1A Antibody) at dilution 1/50, on the right is treated with fusion protein. (Original magnification: ×200)
-
The image on the left is immunohistochemistry of paraffin-embedded Human colon cancer tissue using CSB-PA086956(DCP1A Antibody) at dilution 1/50, on the right is treated with fusion protein. (Original magnification: ×200)
-
Gel: 6%SDS-PAGE, Lysate: 40 μg, Lane: Hela cells, Primary antibody: CSB-PA086956(DCP1A Antibody) at dilution 1/1100, Secondary antibody: Goat anti rabbit IgG at 1/8000 dilution, Exposure time: 10 seconds
-
-
其他:
產(chǎn)品詳情
-
Uniprot No.:
-
基因名:DCP1A
-
別名:DCP1 decapping enzyme homolog A antibody; Dcp1a antibody; DCP1A_HUMAN antibody; Decapping enzyme hDcp1a antibody; Decapping mRNA 1A antibody; HSA275986 antibody; mRNA decapping enzyme 1A antibody; mRNA-decapping enzyme 1A antibody; Nbla00360 antibody; Putative protein product of Nbla00360 antibody; Smad4 interacting transcriptional co activator antibody; Smad4-interacting transcriptional co-activator antibody; Smad4-interacting transcriptional co-activator antibody; SMAD4IP1 antibody; SMIF antibody; Transcription factor SMIF antibody
-
宿主:Rabbit
-
反應(yīng)種屬:Human,Mouse
-
免疫原:Fusion protein of Human DCP1A
-
免疫原種屬:Homo sapiens (Human)
-
標(biāo)記方式:Non-conjugated
-
抗體亞型:IgG
-
純化方式:Antigen affinity purification
-
濃度:It differs from different batches. Please contact us to confirm it.
-
保存緩沖液:-20°C, pH7.4 PBS, 0.05% NaN3, 40% Glycerol
-
產(chǎn)品提供形式:Liquid
-
應(yīng)用范圍:ELISA,WB,IHC
-
推薦稀釋比:
Application Recommended Dilution ELISA 1:2000-1:10000 WB 1:1000-1:5000 IHC 1:100-1:300 -
Protocols:
-
儲(chǔ)存條件:Upon receipt, store at -20°C or -80°C. Avoid repeated freeze.
-
貨期:Basically, we can dispatch the products out in 1-3 working days after receiving your orders. Delivery time maybe differs from different purchasing way or location, please kindly consult your local distributors for specific delivery time.
-
用途:For Research Use Only. Not for use in diagnostic or therapeutic procedures.
相關(guān)產(chǎn)品
靶點(diǎn)詳情
-
功能:Necessary for the degradation of mRNAs, both in normal mRNA turnover and in nonsense-mediated mRNA decay. Removes the 7-methyl guanine cap structure from mRNA molecules, yielding a 5'-phosphorylated mRNA fragment and 7m-GDP. Contributes to the transactivation of target genes after stimulation by TGFB1. Essential for embryonic development.
-
基因功能參考文獻(xiàn):
- Overexpression of DCP1A is associated with malignant melanoma. PMID: 29076924
- The results suggest that overexpressed Dcp1a and GW182 can form different cytoplasmic aggregates and play distinct biological roles in the miRNA pathway. PMID: 28488892
- The E3 ligase TRAF6 binds to DCP1a and indirectly regulates DCP1a phosphorylation, expression of decapping factors, and gene-specific mRNA decay. PMID: 27315556
- DCP1A rs11551405 may have a prognostic effect on survival of CM patients. PMID: 27578485
- The assembly of EDC4 and Dcp1a into processing bodies is critical for the translational regulation of IL-6. PMID: 25970328
- Phosphorylation at serine 315, serine 319, and threonine 321 of DCP1A modulates IL-8 expression during respiratory syncytial virus infection. PMID: 25796077
- The data indicates that DCP2 activation by DCP1 occurs preferentially on the EDC4 scaffold, which may serve to couple DCP2 activation by DCP1 with 5'-to-3' mRNA degradation by XRN1 in human cells. PMID: 24510189
- Malin regulates the recruitment of mRNA-decapping enzyme 1A (Dcp1a) to processing bodies. PMID: 23131811
- hDcp1a has a role in control of processing body dynamics during the cell cycle via phosphorylation PMID: 23300942
- Reveal DCP1a as a multifunctional regulator of mRNA expression and suggest a role for JNK kinase phosphorylation in controlling the subcellular localization of DCP1a in response to stress or inflammatory stimuli. PMID: 21859862
- Data show the presence of P-body-like foci in mouse oocytes, as revealed by the presence of Dcp1a and the colocalization of RNA-associated protein 55 (RAP55) and the DEAD box RNA helicase Rck/p54. PMID: 19812249
- Overexpression of wild-type SMIF enhanced expression of TGFbeta/BMP regulated genes, whereas a dominant-negative SMIF mutant suppressed expression. PMID: 11836524
- These data suggest that a human decapping complex containing decapping enzymes hDcp1a and hDcp2 may be recruited to mRNAs containing premature termination codons by the hUpf proteins. PMID: 12417715
顯示更多
收起更多
-
亞細(xì)胞定位:Cytoplasm, P-body. Nucleus.
-
蛋白家族:DCP1 family
-
組織特異性:Detected in heart, brain, placenta, lung, skeletal muscle, liver, kidney and pancreas.
-
數(shù)據(jù)庫鏈接:
Most popular with customers
-
-
YWHAB Recombinant Monoclonal Antibody
Applications: ELISA, WB, IHC, IF, FC
Species Reactivity: Human, Mouse, Rat
-
Phospho-YAP1 (S127) Recombinant Monoclonal Antibody
Applications: ELISA, WB, IHC
Species Reactivity: Human
-
-
-
-
-